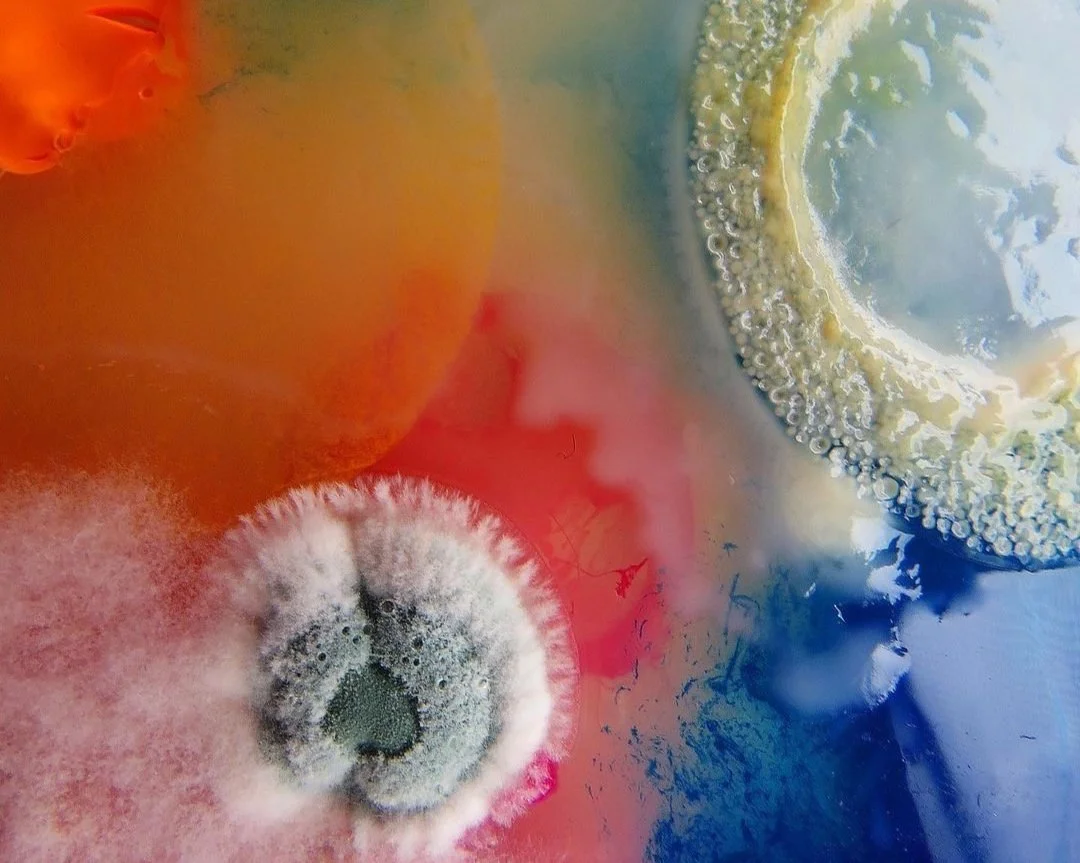

Art and Biology: A Match Made on Earth
“Bio-art can act as an intermediary between non-scientists and science, holding the potential to articulate the ethical and social dilemmas of complicated science and technology. ”
Bio Art is an artistic method that uses nature as inspiration and as a medium, merging the lines between art and biology. It varies from the study of molecular biology, biotechnology, and human science to using elements of nature and highlighting their capabilities. Introducing biology into the art world creates cultural commentary which has reflective and educational properties.
Bio Art emerged through rapid innovations in technology, biology, and the arts, blending human biology, nature, chemistry, and molecular biology. This concept is estimated to have originated in the last four decades of the twentieth century. As the blend of art and biology is introduced, it sparks a conversation about whether the work is now a living being. The work of art can transform and become its own creation beyond its artist. The creation of Bio Art is also an introduction to a new use of languages and ways of viewing the world. It also brings new information to the arts and biology that would only have been explored or even found with these new interactions. These types of work have substantial positive impacts, such as the capacity to educate differently, introduce concepts not grasped daily, appreciate biological factors, and support biological research.
Daria Fedorova, When Mold Is Looking Fabulous! The Microorganism Studies of Daria Fedorova, 2021. Photo Courtesy: Dasha Plesen.
Bio Art also proposes ethical implications as it is now a work that has its own life—bringing into question the bioethical implications of creating a living organism. Who is in charge of taking care of the life and the disposal of it? One of the first well-known examples of Bio Art is GFP Bunny by Eduardo Kac in 2000. The genetically engineered green glowing rabbit was created by combining jellyfish and rabbit DNA, an invention that reached both art and science headlines. Kac’s invention allowed other artists to reflect on their creations and expand on the capacity of a system capable of this interaction between nature and art. Consequently, the lab SymbioticA emerged as “the first research laboratory of its kind, enabling artists and researchers to engage in wet biology practices in a biological science department.” (The University of Western Virginia; SymbioticA) [1] SymbioticA hosts artist and biologist residencies, seminars, courses, and events that educate people on the innovations created by recent residents. With the labs they provide, the artist and biologist have all the tools necessary to carry their research through. It also supports other fields of research, such as Art & Ecology, Bioethics, Neuroscience, Sleep Science, and Tissue Engineering.
This genre of Bio Art has become a global novelty, highlighting the relevance of the conversation between nature, the world around us and humanity. Bio Art drew recent headlines when the artist Precious Okoyomon, Frieze Artist Award Winner, presented a large installation in the Artiglierie space at the Biennale di Venezia 2022. [2] Her work focused on bringing awareness of the importance of nature, its beautiful chaos, and its destruction. She studies the properties of the plants installed and how they evolve and interact to create her own flourishing environments. Within these environments, she proves her hypothesis that nature is nurturing, giving, and flourishing. With the passage of time in the installation, insects and new life emerges. These ecosystems bring the wonder of the outside indoors.
Installation View of Precious Okoyomon’s To See The Earth Before the End of the World, 2022. Photo Courtesy: Dozier. Artsy.
Bio Art is also relevant regarding questions of sustainability in the Art World. The artist couple Mayer and Newton Harrison are focusing on exploring Bio Art as a medium of education and research to impact climate change. Their projects have ranged from the restoration of rivers to urban planning projects. Creating an impact with their work on communities, cultures, and the climate makes the viewers question the definition of what art is.
Meanwhile, there are also positive impacts on sustainable food systems, created by an exhibition on agricultural technology in 2022 by Ionat Zurr and Oron Catts in collaboration with Steve Berrick and supported by SymbioticA. These examples of modern Bio Art redefine the capacities of art as environmentally transformative.
The previously mentioned Bio Artists are actively influencing nature; meanwhile, artists like Xiaojing Yan and Tuomas A. Laitinen are creating exhibitions that spotlight the natural world's generative power and aesthetics. Xiaojing Yan uses lingzhi mycelium instead of a brush and paints to create sculptures that change within time into mushroom meccas where the windows of the original sculpture come through. [3] Tuomas A. Laitinen creates art by investigating octopuses by “exploring the entanglements of multispecies coexistence.” (Tuomas et al.; About)[4]. Both artists have addressed current calls for sustainability and awareness of climate change through the pure appreciation of nature's capabilities. Through art, people are introduced to the details and innovations of nature in a way that could not be experienced by just reading, hearing, or seeing texts, charts, and data. These artworks become living testaments to the sublime power of nature.
XiaoJing Yan, Lingzhi Girl, 2020. Photo courtesy: XiaoJing Yan.
Tuomas A. Laitinen, Habitat Cascade, 2019. Photo Courtesy: Tuomas A. Laitinen.
Lastly, artists such as Daria Fedorova focus on the smallest parts of nature: microorganisms. She is based in Moscow and works with nurturing and cultivating microorganisms to create natural abstractions in Petri dishes. [5] She modifies the different air and surrounding samples with the use of dyes and reactions in order to create a varied textured composition. By focusing on details, she can bring to attention how even the smallest part of our world is alive and within themselves, and they can create art if given the medium to do so.
Daria Fedorova, Nutrient, spores, 2 weeks of incubation, 2021. Photo courtesy: Drone.tv, n.d. [6]
Bio Art raises a multitude of questions. Do artists have a right to use living organisms, microbes, and nature? Is there room for future innovations? Is there a part of the conversation that needs to be included, as there are no fully established means of communication with the species being worked with? They are still unanswered, but having them is crucial for Bio Art to endure as a lasting practice. The emergence of this new genre of art sparks fascinating conversations about the human consciousness and our existence in the living world. Bio Art has the capacity to touch upon human emotions and the natural curiosity we have towards nature. Bio Art expands the mediums used for art creation, unlocking completely new artworks and ways to experience them. It is an ode to what the world has to give and how we decide to see it.
Footnotes:
The University of Western Australia. n.d. “SymbioticA.” Www.symbiotica.uwa.edu.au. https://www.symbiotica.uwa.edu.au/.
Dozier, Ayanna. 2022. “Precious Okoyomon Ushers Dirt, Blood, and Butterflies into the Venice Biennale.” Artsy. April 21, 2022. https://www.artsy.net/article/artsy-editorial-precious-okoyomon-ushers-dirt-blood-butterflies-venice-biennale.
“Lingzhi Girl Time Lapse.” n.d. XIAOJING YAN. Accessed November 27, 2023. https://yanxiaojing.com/works/lingzhi-girl-time-lapse/.
“TAL.” n.d. www.tuomasalaitinen.com. Accessed November 27, 2023. http://www.tuomasalaitinen.com/.
“When Mold Is Looking Fabulous! The Microorganism Studies of Daria Fedorova.” 2021. TRENDLAND | Online Trend News. September 22, 2021. https://trendland.com/when-mold-is-looking-fabulous-the-microorganisms-by-dasha-plesen/.
drone.tv. n.d. “Daria Fedorova.” Med in Art. https://medinart.eu/works/daria-fedorova/.
To discover more about SymbioticA please visit the SymbitoticA website.
Celeste Melgar
Features Co-Editor, MADE IN BED